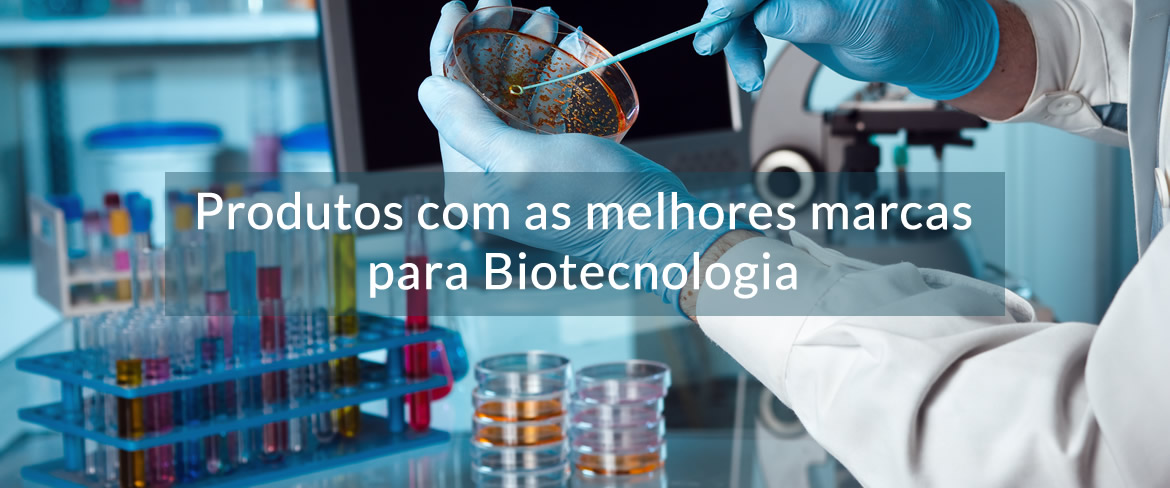

As melhores marcas e produtos para Laboratório
Para atingir nossos objetivos, trabalhamos com algumas das mais proeminentes, prestigiadas e respeitadas marcas e fabricantes em todo o mundo.
Nossos Produtos
Conheça nossa vasta linha de produtos para laboratórios das mais conceituadas marcas do mercado. Entre nossos principais produtos está a área de produtos químicos para laboratórios e artigos de vidro.
Conheça nossos Produtos

Nossos Fornecedores
A Chempex Brasil é um distribuidor líder de linha completa de suprimentos de laboratório em geral, trabalhando com as melhores marcas e fabricantes do mercado de laboratórios.
Conheça nossos FornecedoresVendas Chempex: (11) 2440-8393 | vendas@chempex.com.br
Quem Somos
Em 2016, depois de uma carreira bem-sucedida na Sigma, fundou uma empresa de distribuição científica, fornecendo principalmente produtos químicos para laboratório e artigos de vidro. A Chempex Brasil é um distribuidor líder de linha completa de suprimentos de laboratório em geral.
Conheça a ChempexPrincipais Marcas